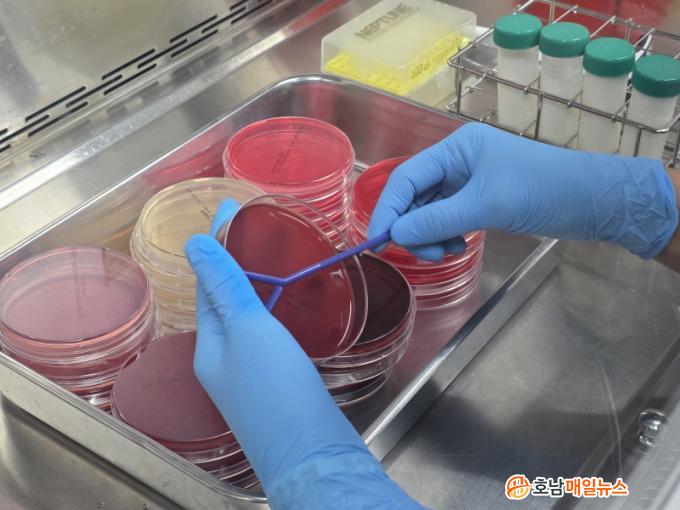

|
Àü³²µµµ¿¹°À§»ý½ÃÇè¼Ò´Â ¿Ã ÇÏ¹Ý±â °Ë»ç ¼Óµµ¿Í Á¤È®¼ºÀÌ ³ôÀº ü¼¼Æ÷¼ö ÀÚµ¿°Ë»ç±â¿Í À¯¼ººÐ ºÐ¼®±â µî ÃֽŠÀåºñ¸¦ ½Å±Ô µµÀÔÇß´Ù. À̸¦ Åä´ë·Î öÀúÇÑ ¿øÀ¯ °ø¿µÈ °Ë»ç¸¦ ¼öÇàÇϰí ÀÖ´Ù.
Á¥¼Ò À¯¹æ¿°Àº ¼¼±Õ¡¤°õÆÎÀÌ µî ¹Ì»ý¹°ÀÇ À¯¹æ ħÀÔÀ¸·Î ¹ß»ýÇϸç, ¿øÀ¯ »ý»ê·® °¨¼Ò¿Í ¼¼±Õ¼ö¡¤Ã¼¼¼Æ÷¼ö Áõ°¡·Î ǰÁúÀ» ¶³¾î¶ß¸°´Ù. ³ó°¡ °¨¿° È®»ê, µµÅÂÀ² Áõ°¡, Ä¡·áºñ ºÎ´ã µî Á÷¡¤°£Á¢ ÇÇÇØµµ Å©´Ù.
ÃÖ±Ù¿¡´Â Æ÷µµ¾Ë±Õ¼Ó, Ȳ»öÆ÷µµ¾Ë±Õ, ´ëÀå±Õ µî ´ëÇ¥Àû ¿øÀαջӸ¸ ¾Æ´Ï¶ó ȯ°æ¼º ¿¬¼â¾Ë±Õ¡¤Àå¾Ë±Õ µî ȯ°æ¼º ¼¼±Õ¿¡ ÀÇÇÑ ¹ßº´µµ ´Ã¾î ³«³ó°¡ »ç¾ç¡¤À§»ý °ü¸®ÀÇ Á߿伺ÀÌ ³ô¾ÆÁö°í ÀÖ´Ù.
ÀÌ¿¡ µû¶ó Àü³²µµµ¿¹°À§»ý½ÃÇè¼Ò´Â ¸ÅÁÖ »ý»ê ¿øÀ¯ÀÇ ¼¼±Õ¼ö¡¤Ã¼¼¼Æ÷¼ö¸¦ ºÐ¼®ÇØ À§»ýµî±ÞÀ» Æò°¡Çϰí, À¯¹æ¿° ¿øÀÎ±Õ Áø´Ü°ú Ç×»ýÁ¦ °¨¼ö¼º °Ë»ç·Î ³ó°¡¿Í °³Ã¼º° ÃÖÀû Ä¡·áÁ¦¸¦ ¾È³»Çϰí ÀÖ´Ù. Ãà»ç ȯ°æ °³¼±, ¼Òµ¶ °È, ÂøÀ¯ À§»ý°ü¸® ±³À° µî ¿¹¹æ Áöµµµµ ÇÔ²² ÆîÄ¡°í ÀÖ´Ù.
Á¤Áö¿µ Àü³²µµµ¿¹°À§»ý½ÃÇè¼ÒÀåÀº ¡°°Ü¿ïöÀº ³·Àº ±â¿Â°ú Ãà»ç ȯ°æ º¯È·Î ¿øÀ¯ À§»ý°ú ǰÁú¿¡ ¼¼½ÉÇÑ ½Å°æÀ» ½á¾ß ÇÒ ½Ã±â¡±¶ó¸ç ¡°½Å±Ô Àåºñ¿Í ü°èÀû °Ë»ç·Î ³ó°¡ ÇÇÇØ¸¦ ÃÖ¼ÒÈÇÏ°í ¾ÈÀüÇÑ ¿ìÀ¯ »ý»ê¿¡ ÃÖ¼±À» ´ÙÇϰڴ١±°í ¸»Çß´Ù.
ÃÖ±Ù Àü³²Áö¿ª 220°³ Á¥¼Ò ³ó°¡ ¿øÀ¯´Â ¼¼±Õ¼ö 1µî±Þ 98%, ü¼¼Æ÷¼ö 1µî±Þ 64%¸¦ ±â·ÏÇß´Ù.
2026.01.20 (È) 22:17